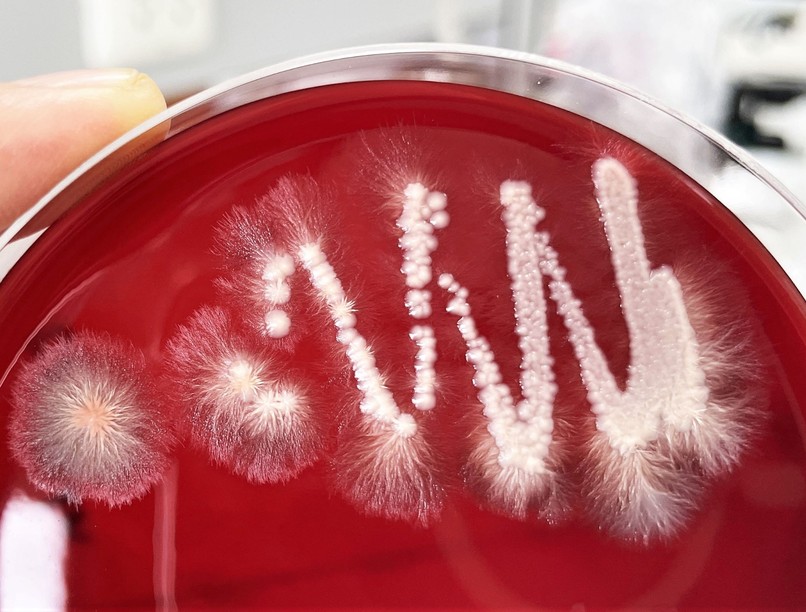
candida, Candida albicans, élesztőgomba, Candida-diéta, fertőzés

Évekkel ezelőtt úgy tekintettek a Candida albicans élesztőgombára, mint számos panasz okára. Ma már másként értékelik a „gombás” állapotot, és másként zajlik a kezelése is.
A Candida-diéta is kiment már a divatból. Tény azonban, hogy a megfelelő táplálkozás és bizonyos étrend-kiegészítők fogyasztása – a gyógyszeres kezelés mellett – támogathatja a gyógyulást, és hozzájárulhat egy újabb fertőzés megelőzéséhez.
Gomba-fóbia: volt és van is?
Egy-két évtizedet visszaugorva az időben azt látjuk, hogy a természetgyógyászok és laikusok tömkelege már-már mániákusan (székletpróbákkal, nyáltesztekkel és egyéb módszerekkel) kereste a különféle panaszokkal rendelkezők szervezetében a gombák jelenlétének jeleit. Úgy gondolták, hogy az élesztőgombák, elsősorban a Candida fajok (pl. Candida albicans) túlszaporodása és az általuk termelt vegyületek felelnek a teltségérzetért, a puffadásért, a hasi fájdalmakért vagy a levertségért éppen úgy, mint a migrénért, a viszketésért vagy az ízületi fájdalmakért.
Ma már tudjuk, hogy ez a fajta „gomba-fóbia” eltúlzott mértékű volt, hiszen például a puffadás vagy a teltségérzet okai szerteágazók lehetnek, illetve a székletből történő gombakimutatás önmagában nem jelent diagnózist, hiszen az nem igazol ok-okozati kapcsolatot. Bebizonyosodott, hogy a Candida gombafajok az emberek nagy részének bélcsatornájában jelen vannak anélkül, hogy betegségre utaló tüneteket okoznának.
Korábban a szigorúan cukormentes táplálkozást, a gombaellenes diétát tekintették a legjobb terápiás eszköznek. A cukormentes étrend célja a gombák kiéheztetése és elpusztítása volt. Az interneten még ma is számos Candida-diétás recept lelhető fel. A szakemberek és a szakmai szervezetek azonban ma már megkérdőjelezik ennek a fajta „kiéheztetéses” diétának a hasznosságát; ugyanis a szénhidrátbevitel szigorú korlátozása az emberi szervezetben is károsodásokat okozhat.
A Candidával együtt lehet élni, ameddig kordában tartható
Az élesztőgombák, köztük a Candida fajok széles körben elterjedtek, mind az emberek, mind az állatok, mind a növények körében. Többek között az élelmiszeripar is él a sör- és élesztőgombák nyújtotta lehetőségekkel.
Ráadásul, a Candida gombák nem teljesen testidegenek. A Candida nem szükségszerűen kórokozó! Az emberi szervezet számos régióját, egészséges egyéneknél is, élesztőgombák népesítik be. Talán meglepő, de az egészséges emberek körülbelül 60-75 %-ának a szájüregi és garati nyálkahártyáján, a genitális régiójában (pl. hüvelyében), illetve a vastagbelében kimutatható a Candida albicans jelenléte. Hangsúlyozandó tehát, hogy akinek a szervezetéből kimutatható a Candida, az közel sem biztos, hogy Candida-fertőzött.
Röviden azt lehet mondani, hogy a Candida gombákkal együtt lehet élni – békében; egészen addig, ameddig a Candida elszaporodása kordában tartható. Ha egészséges a bél, a hüvely vagy a szájüreg flórája, akkor a Candida nem szaporodhat el benne kóros mértékben, mert a többi ott jelenlévő mikroorganizmus gátat szab neki. A baj akkor lép fel, ha ez a gát megszűnik, és a Candida gomba aránytalanul elszaporodik a bélben, a hüvelyben vagy a bőrön, és ott dominánssá válik, tüneteket okoz.
Kinél lehetnek veszélyesek a gombák?
A Candida-okozta problémák elsősorban a károsodott immunfunkciójú egyéneknél, így például a HIV-fertőzötteknél, a diabéteszeseknél, illetve a daganatos betegeknél léphetnek fel. Emellett, az életkor is befolyásoló: az átlagosnál nagyobb mértékben kitettek a gombás fertőzéseknek az időskorúak, illetve az újszülöttek, a csecsemők.
Bizonyos gyógyszerek szedése is hajlamosít gombás infekciókra: ide sorolhatók az antibiotikumok, a gyulladáscsökkentő szteroidok (=glükokortikoidok), az immunszuppresszáns szerek, de akár a fogamzásgátlók szedése is gyakoribbá teheti a gombás fertőzéseket.
A rizikócsoportba sorolt személyeknél a gombák túlszaporodása tipikus tünetekkel, például
- szájpenészesedéssel,
- hüvelygombásodással,
- végbéltáji viszketéssel járhat.
- Súlyosabb esetekben a gombák a vérkeringés révén különféle belső szerveket is elérhetnek, azok károsodását okozhatják.
Ez utóbbi elsősorban az intenzív betegellátó osztályokon ápolt pácienseknél jelent problémát. A belső szervi gombásodást tovább súlyosbítja az a tény, hogy az elmúlt években egyre nagyobb számban és arányban jelennek meg Európa-szerte is a különféle gombaellenes gyógyszerekkel szemben ellenálló, ún. rezisztens Candida-fajok. Ezek akár halálos kimenetelű fertőzéseket is okozhatnak.
A Candida-fertőzés jelei
A Candida túlszaporodása jellegzetes tüneteket okozhat attól függően, hogy melyik testtájon szaporodik el túlságosan.
- A szájüregben, a szájnyálkahártyán letörölhető, fehéres színű lepedék jelenik meg. A szájpenész különösen gyakori újszülött- és csecsemőkorban, de idős, protézist viselő embereknél is előfordulhat, csakúgy, mint immunrendszert gyengítő gyógyszerek mellékhatásaként. A steril mull-lapos „kitörlés” mellett antiszeptikus szájöblögetés alkalmazható. Nem árt tudni, hogy a korábban a csecsemőknél alkalmazott bóraxos kezelésnek, az ún. rózsaméznek az alkalmazását a közelmúltban betiltották.
- A lábujjak és a kézujjak között is kialakulhat Candida okozta fertőzés; elsősorban a cukorbeteg, kövér, sokat izzadó egyéneknél. A sok kézmosás csak ront a helyzeten; így azok különösen gyakoriak háziasszonyoknál, cukrászoknál, szakácsoknál. Az érintettek gyulladt, rendkívül erősen viszkető ujjközökről számolnak be.
- A nedves, összefekvő, meleg bőrterületek (combtő, mell alatt stb.) is melegágyai lehetnek a Candida-okozta bőrfertőzéseknek. Tény azonban, hogy a sarjadzó gombák okozta bőrfertőzések gyakoribbak, mint az élesztőgombák, így a Candida-okozta okozta fertőzések. Candida-okozta bőrfertőzésnél a gombaellenes helyi gyógyszeres kezelések alkalmazása javasolt. Sok szakember preferálja a nedvességet felszívó, gombaellenes hintőporok használatát.
- Candida-túlszaporodás gyakran alakulhat ki a hüvelyben, a hüvelyflóra felborulása következtében. A sűrűn folyó, túrószerű, fehéres színárnyalatú hüvelyi folyás, amely jellemzően szagtalan, ugyanakkor erős viszketéssel, égő érzéssel és kipirosodással társul, általában hüvelyi gombás fertőzésre utal. A gombás intim fertőzés patikában vény nélkül is kapható gombaellenes szerekkel kezelhető. Emellett, a hüvelyflóra helyreállítását célzó, hüvelyi pre- és probiotikumos kezelés javasolható.
- A bélben is elszaporodhatnak a Candida-gombák, amelyek puffadást, hasmenést esetleg székrekedést okozhatnak, amely alvászavarokkal, fejfájással, viszketéssel, hangulati zavarokkal társulhat. A bélben kialakuló candidiasis megállapítása igen nagy kihívás, hiszen a tünetek nem tipikusak, és azok szabadon kombinálódhatnak egymással. Nehezíti a diagnózist, hogy a Candida-gombák nagyon sok ember bélcsatornájában jelen vannak, különösebb tünetek jelentkezése nélkül.
- Egyes esetekben végbéltáji tünetekkel, elsősorban kipirosodással és viszketéssel jelezhet a Candida-gomba.
Gombaellenes gyógyszeres kezelés
A Candida-okozta panaszok kezelését orvossal vagy gyógyszerésszel kell egyeztetni. A saját elgondolás alapján történő terápia kerülendő!
Igazolt gombás fertőzés esetén, vagyis, ha a Candida gomba olyan mértékben elszaporodik, hogy az egyéb mikroorganizmusok rovására megy, és gyulladásos folyamatokat is kivált, gombaellenes gyógyszeres kezelésre, ún. antimikotikum alkalmazására kerül sor. A fertőzés helyétől és súlyosságától függően vagy helyileg (pl. bőrön vagy hüvelyben), vagy szájon át alkalmazható antimikotikus hatóanyag. A kezelések időtartama általában néhány hét, azonban a gyógyulási folyamat alatt és azt követően is érdemes odafigyelni életmódbeli tényezőkre.
A gyógyszeres kezelés mellett szükség van az immunrendszer megerősítésére, és az adott flóra, vagyis a bélflóra, a bőrflóra, a szájüregi flóra és/vagy a hüvelyflóra egyensúlyának helyreállítására. Ebből a célból javasolt a pre- és probiotikumos készítmények alkalmazása. Egyes vizsgálatok a Lactobacillus acidophilus, a Lactobacillus casei, illetve a Saccharomyces cerevisiae var. boulardii alkalmazásához kötnek pozitív hatást.
Továbbá, érdemes bizonyos diétás szabályokat követni. Vizsgálatok is bizonyítják, hogy a gyógyszerek mellett alkalmazott diéta hosszú távon kedvezőbb hatású, mint az önmagában alkalmazott gyógyszeres kezelés.
Mi a diéta lényege?
Olyan ételeket kell fogyasztani, amik a saját, egészséges flórát támogatják, és ilyen módon háttérbe szorítják a Candida gombát, megakadályozzák annak térnyerését és azt, hogy panaszokat okozhasson. Tekintettel arra, hogy a Candida-okozta tünetek kezelését illetően rengeteg téves információ lelhető fel, tudni kell, hogy milyen táplálkozási változtatások javasolhatók, és milyen patikaszerek vethetők be a gyorsabb és tartósabb gyógyulás érdekében.
Mit együnk, ha Candidásak vagyunk?
A szénhidrátok teljes mellőzése már a múlté, bizonyított ugyanis, hogy azzal nem csak a Candida gombáknak árt a diétázó személy, hanem saját magának is.
Javasolható ellenben a rostokban dús, teljes kiőrlésű pékárukat tartalmazó és a friss gyümölcsökben dús étrend. A bélflóra támogatása révén előtérbe kerül a flavonoidokban gazdag vöröses és lilás színű zöldség- és gyümölcsfélék (pl. szőlő, egyéb bogyósok), a karotinoidokban dús zöldségek (pl. spárga, sárgarépa) fogyasztása. Emellett érdemes a fitoösztrogénekben gazdag lenmag vagy kagylófélék étrendben való szerepeltetése. A káposztafélék fogyasztása is jótékony hatású lehet, míg mások a spárga és zab fogyasztásáról nyilatkoznak pozitívan.
Az élőflórás kefir és a joghurt fogyasztása, valamint a fermentált élelmiszerek (pl. savanyú káposzta) is hozzájárulhatnak a bakteriális sokszínűség és az egészséges bakteriális flórák kialakulásához.
A fűszernövények (pl. szegfűszeg, zöldcitrom, koriander, fahéj) illóolajainak összetevői hatásosnak tűnnek a Candida ellen. Ezek a növényi anyagcseretermékek nem csak gátolni képesek a Candida-k növekedését, de el is pusztíthatják azokat.
Gyógynövények és esetlegesen kedvező hatású patikaszerek
A szakirodalom a következőkben felsoroltakkal kapcsolatban jelzett/jelez esetlegesen kedvező hatást (a felsorolás nem teljes). Ezeknek a táplálkozásba való beiktatása, étrend-kiegészítőként való alkalmazása megfontolható:
- rezveratrol, amely a vörös szőlőből kivont antioxidáns hatású vegyület,
- laktoferrin,
- kókuszzsír,
- fokhagymakivonat,
- kanadai aranygyökér (Hydrastis canadensis).
Megéri odafigyelni a tisztálkodásra, testápolásra is
A bőr kémhatása optimális esetben enyhén savas. Megfigyelték, hogy azokban a kórképekben (pl. cukorbetegség), amelyeknél a bőr kémhatása emelkedik, nő a bőrgombásodás kockázata. A tisztálkodáshoz és bőrápoláshoz használt termékek megválasztása során – a gombás panaszok megelőzése céljából is - ajánlott tekintettel lenni azok kémhatására. Óvni kell a bőr természetes savköpenyét, és előnyben részesítendők az enyhén savas kémhatású (pH=5,5) tisztálkodószerek.
Hasonlóképpen kell vigyázni a hüvely természetesen savas kémhatására (kb. pH=5) is, és nem szabad azt lúgos irányba eltolni hagyományos szappanok, intim dezodorok vagy gyakori hüvelyi irrigálás alkalmazásával.
Összegezve
- A Candida albicans élesztőgomba szerepe és kezelése változásokon ment keresztül az évek során.
- A Candida-diéta már nem divatos, de a megfelelő táplálkozás és étrend-kiegészítők segíthetnek a gyógyulásban.
- Az élesztőgombák jelenléte az emberek nagy részének bélcsatornájában normális és nem feltétlenül okoz betegségre utaló tüneteket.
- A szigorú cukormentes diéta már nem tekintendő a legjobb terápiás eszköznek a Candida fertőzés kezelésére.
- A Candida okozta problémák elsősorban károsodott immunfunkciójú, időskorú és újszülött betegeknél, valamint bizonyos gyógyszerek szedése is hajlamosíthat a gombás infekciókra.
Olvasta már?
- Candida-fertőzés: oka, tünete és kezelése
- Nyelőcső-candidiasis: a nyelőcső candida oka, tünete és kezelése
- Szájpenész: oka, tünetei, kialakulása és kezelése

Candida-gomba: ezt írja fel ellene az orvos, ha nagyon elszaporodik
Hivatkozás:
The dietary modification and treatment of intestinal Candida overgrowth - a pilot study - PubMed
Kövesse az Egészségkalauz cikkeit a Google Hírek-ben, a Facebook-on, az Instagramon vagy a X-en,Tiktok-on is!